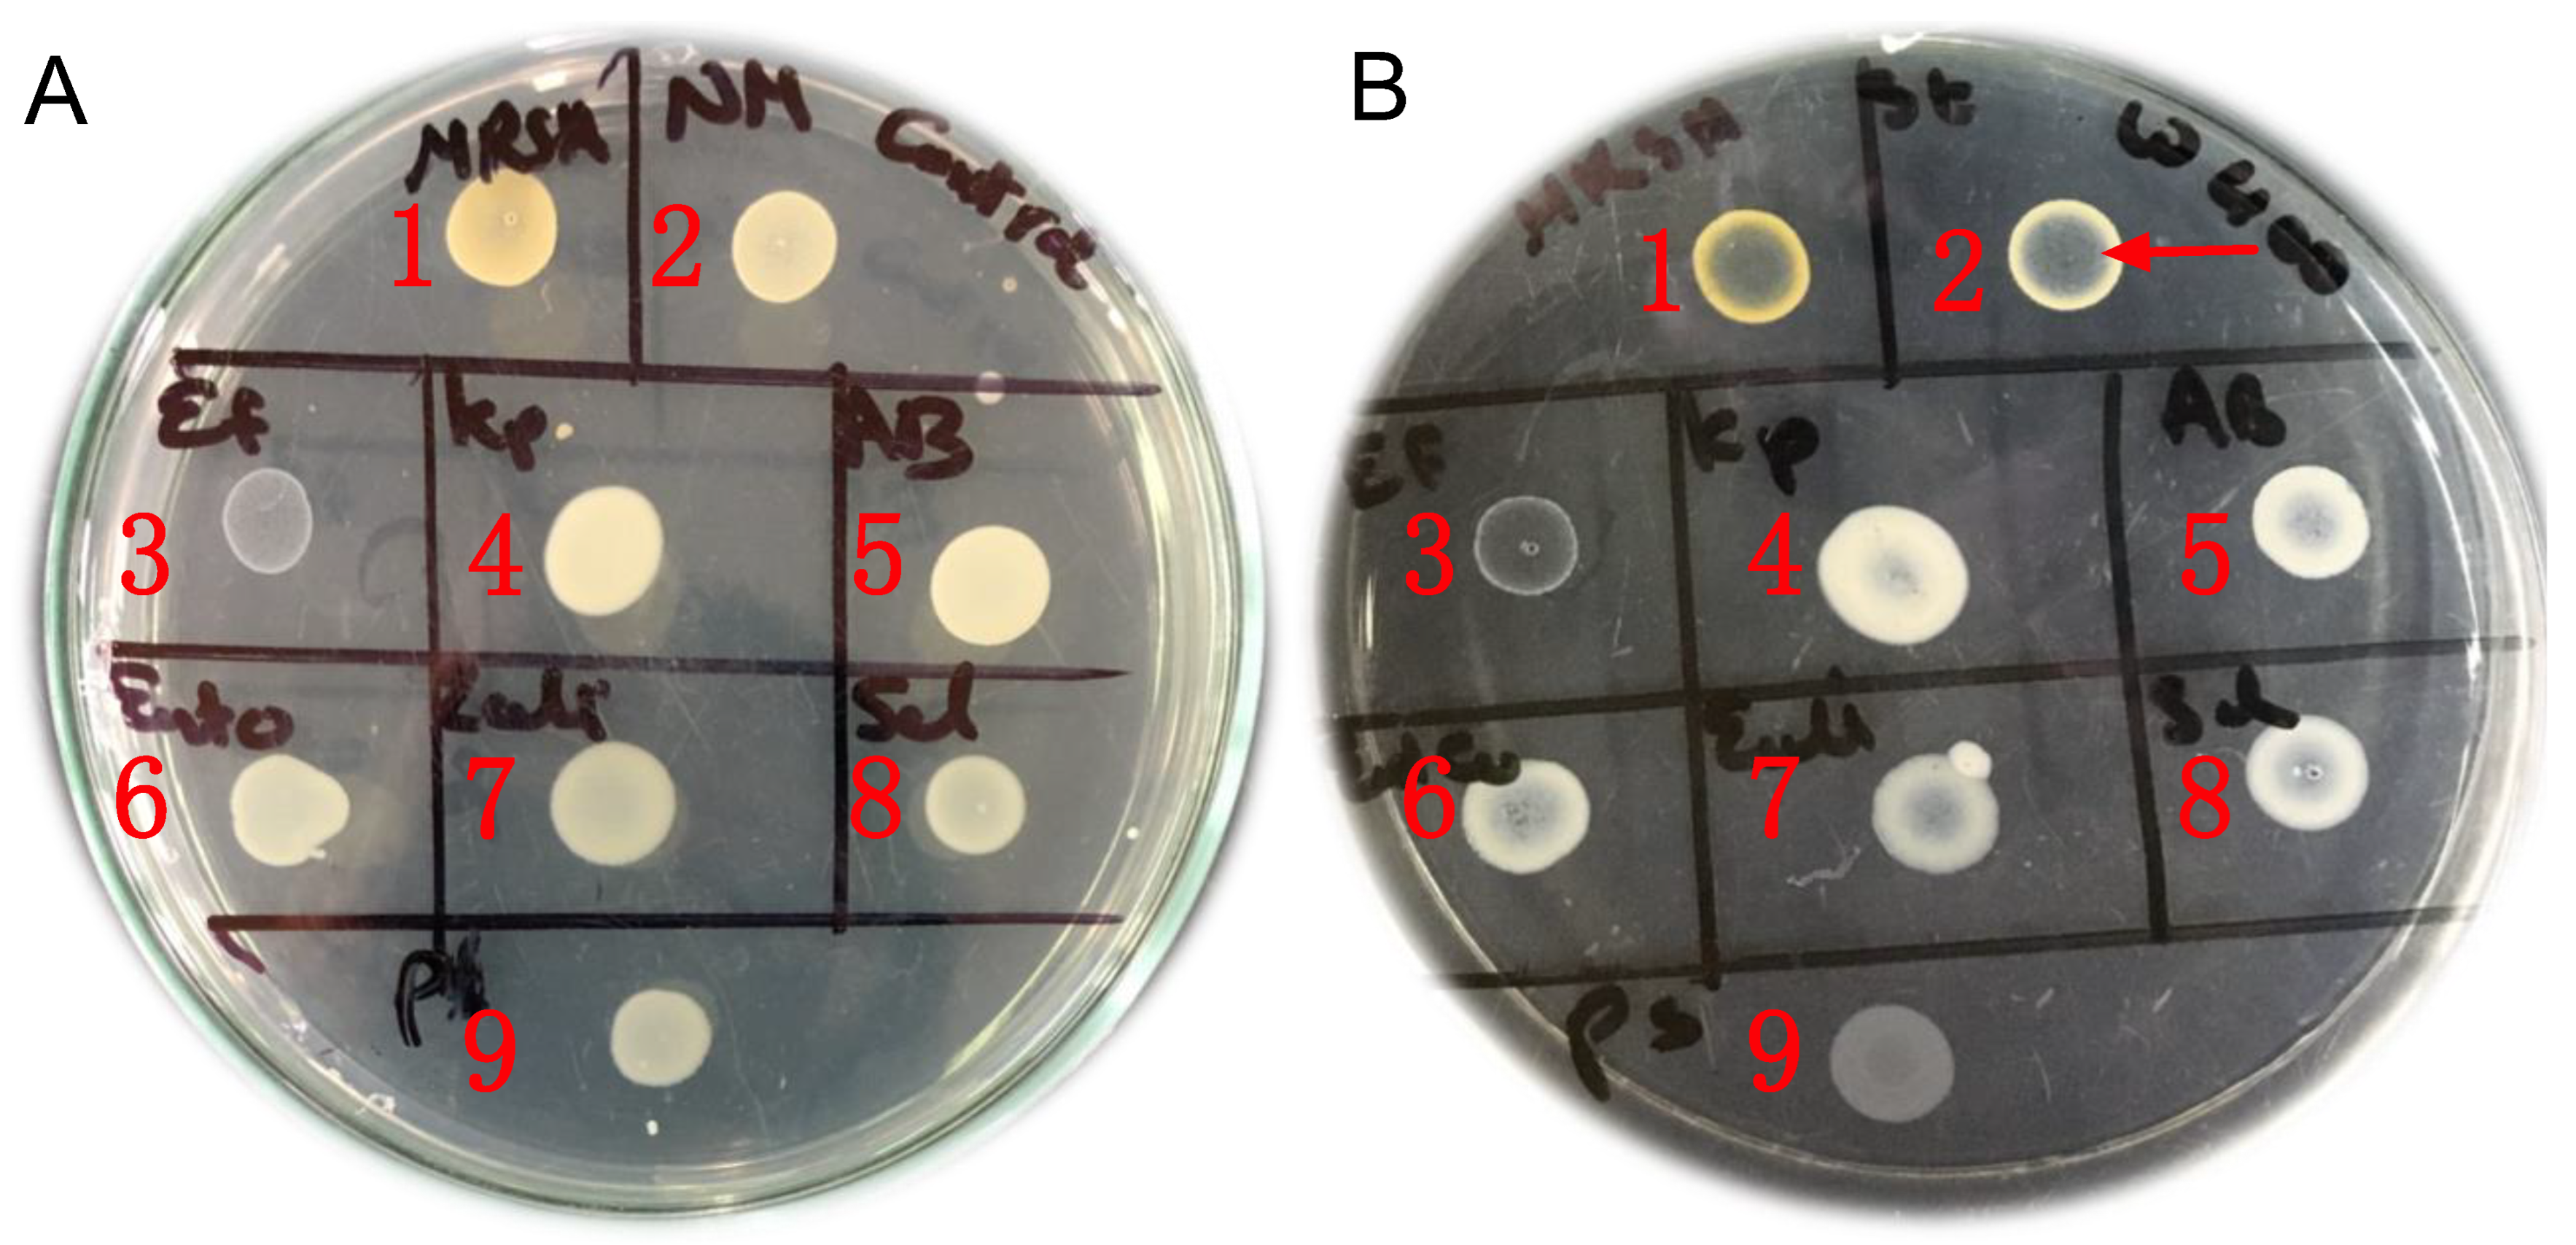

Unveiling Antimicrobial and Antioxidant Compositional Differences between Dukkah and Za’atar via SPME-GCMS and HPLC-DAD
Abstract
1. Introduction
2. Results and Discussion
2.1. Volatile Components and Their Influence on the Aroma of Egyptian Dukkah and Syrian Za’atar via SPME Analysis
2.2. Phenolic Profile in Egyptian Dukkah and Syrian Za’atar (ug/g)
2.3. Vapor-Phase Minimum Inhibitory Concentration (VP-MIC)
2.4. Antioxidant Potential of Egyptian Dukkah and Syrian Za’atar
3. Material and Methods
3.1. Material
3.1.1. Herbal Blends Preparation
3.1.2. Bacterial Strains
3.2. SPME Volatiles Analysis
3.3. GCMS Analysis
3.4. Determination of Phenolic Compounds Using HPLC-DAD
3.5. Vapor-Phase Antibacterial Activity of the Tested Mixtures
Vapor-Phase Minimum Inhibitory Concentration (VP-MIC)
3.6. Antioxidant Potential of the Tested Herbal Mixtures
3.6.1. DPPH Free Radical Scavenging Activity
3.6.2. ABTS Assay
3.6.3. Oxygen Radical Absorbance Capacity (ORAC) Assay
3.6.4. The Ferric Reducing Ability of Plasma (FRAP Assay)
3.6.5. Ferrozine Iron Metal Chelation Assay
4. Conclusions
Author Contributions
Funding
Institutional Review Board Statement
Informed Consent Statement
Data Availability Statement
Acknowledgments
Conflicts of Interest
Sample Availability
References
- Fehér, A.; Gazdecki, M.; Véha, M.; Szakály, M.; Szakály, Z. A Comprehensive Review of the Benefits of and the Barriers to the Switch to a Plant-Based Diet. Sustainability 2020, 12, 4136. [Google Scholar] [CrossRef]
- Tuso, P.; Stoll, S.R.; Li, W.W. A plant-based diet, atherogenesis, and coronary artery disease prevention. Perm. J. 2015, 19, 62. [Google Scholar] [CrossRef] [PubMed]
- McMacken, M.; Shah, S. A plant-based diet for the prevention and treatment of type 2 diabetes. J. Geriatr. Cardiol. 2017, 14, 342. [Google Scholar]
- Ostfeld, R.J. Definition of a plant-based diet and overview of this special issue. J. Geriatr. Cardiol. 2017, 14, 315. [Google Scholar]
- Hemler, E.C.; Hu, F.B. Plant-based diets for personal, population, and planetary health. Adv. Nutr. 2019, 10, S275–S283. [Google Scholar] [CrossRef] [PubMed]
- Khalil, M.; Caponio, G.R.; Diab, F.; Shanmugam, H.; Di Ciaula, A.; Khalifeh, H.; Vergani, L.; Calasso, M.; De Angelis, M.; Portincasa, P. Unraveling the beneficial effects of herbal Lebanese mixture “Za’atar”. History, studies, and properties of a potential healthy food ingredient. J. Funct. Foods 2022, 90, 104993. [Google Scholar] [CrossRef]
- Mohamed, R.S.; Abdel-Salam, A.M. Efficiency of a formulated condiment (duqqa) in mitigation of diabetes and its complications induced by streptozotocin-nicotinamide in rats. J. Herbmed Pharmacol. 2021, 10, 218–225. [Google Scholar] [CrossRef]
- Goñi, P.; López, P.; Sánchez, C.; Gómez-Lus, R.; Becerril, R.; Nerín, C. Antimicrobial activity in the vapour phase of a combination of cinnamon and clove essential oils. Food Chem. 2009, 116, 982–989. [Google Scholar] [CrossRef]
- Tzima, K.; Makris, D.; Nikiforidis, C.V.; Mourtzinos, I. Potential use of rosemary, propolis and thyme as natural food preservatives. J. Nutr. Health 2015, 1, 6. [Google Scholar]
- Fazeli, M.R.; Amin, G.; Attari, M.M.A.; Ashtiani, H.; Jamalifar, H.; Samadi, N. Antimicrobial activities of Iranian sumac and avishan-e shirazi (Zataria multiflora) against some food-borne bacteria. Food Control 2007, 18, 646–649. [Google Scholar] [CrossRef]
- Silva, F.; Domingues, F.C. Antimicrobial activity of coriander oil and its effectiveness as food preservative. Crit. Rev. Food Sci. Nutr. 2017, 57, 35–47. [Google Scholar] [CrossRef] [PubMed]
- Laird, K.; Phillips, C. Vapour phase: A potential future use for essential oils as antimicrobials? Lett. Appl. Microbiol. 2012, 54, 169–174. [Google Scholar] [CrossRef] [PubMed]
- Afifi, S.M.; El-Mahis, A.; Heiss, A.G.; Farag, M.A. Gas chromatography–mass spectrometry-based classification of 12 fennel (Foeniculum vulgare Miller) varieties based on their aroma profiles and estragole levels as analyzed using chemometric tools. ACS Omega 2021, 6, 5775–5785. [Google Scholar] [CrossRef] [PubMed]
- Horváth, G.; Horváth, A.; Reichert, G.; Böszörményi, A.; Sipos, K.; Pandur, E. Three chemotypes of thyme (Thymus vulgaris L.) essential oil and their main compounds affect differently the IL-6 and TNFα cytokine secretions of BV-2 microglia by modulating the NF-κB and C/EBPβ signalling pathways. BMC Complement. Med. Ther. 2021, 21, 148. [Google Scholar] [CrossRef] [PubMed]
- Guo, F.; Chen, Q.; Liang, Q.; Zhang, M.; Chen, W.; Chen, H.; Yun, Y.; Zhong, Q.; Chen, W. Antimicrobial activity and proposed action mechanism of linalool against Pseudomonas fluorescens. Front. Microbiol. 2021, 12, 562094. [Google Scholar] [CrossRef] [PubMed]
- Carson, C.F.; Riley, T.V. Antimicrobial activity of the major components of the essential oil of Melaleuca alternifolia. J. Appl. Bacteriol. 1995, 78, 264–269. [Google Scholar] [CrossRef]
- Qi, S.; Zhan, P.; Tian, H.; Wang, P.; Ma, X.; Li, K. Effects of thyme (Thymus vulgaris L.) addition on the volatile compounds of mutton broth during boiling. Food Sci. Hum. Wellness 2022, 11, 305–315. [Google Scholar] [CrossRef]
- Aljaafari, M.N.; Alkhoori, M.A.; Hag-Ali, M.; Cheng, W.-H.; Lim, S.-H.-E.; Loh, J.-Y.; Lai, K.-S. Contribution of Aldehydes and Their Derivatives to Antimicrobial and Immunomodulatory Activities. Molecules 2022, 27, 3589. [Google Scholar] [CrossRef]
- Morshedi, D.; Aliakbari, F.; Tayaranian-Marvian, A.; Fassihi, A.; Pan-Montojo, F.; Pérez-Sánchez, H. Cuminaldehyde as the major component of Cuminum cyminum, a natural aldehyde with inhibitory effect on alpha-synuclein fibrillation and cytotoxicity. J. Food Sci. 2015, 80, H2336–H2345. [Google Scholar] [CrossRef]
- Monteiro-Neto, V.; de Souza, C.D.; Gonzaga, L.F.; da Silveira, B.C.; Sousa, N.C.F.; Pontes, J.P.; Santos, D.M.; Martins, W.C.; Pessoa, J.F.V.; Carvalho Junior, A.R. Cuminaldehyde potentiates the antimicrobial actions of ciprofloxacin against Staphylococcus aureus and Escherichia coli. PLoS ONE 2020, 15, e0232987. [Google Scholar]
- Farag, M.A.; Fayek, N.M.; Abou Reidah, I. Volatile profiling in Rhus coriaria fruit (sumac) from three different geographical origins and upon roasting as analyzed via solid-phase microextraction. PeerJ 2018, 6, e5121. [Google Scholar] [CrossRef] [PubMed]
- Shi, C.; Zhao, X.; Meng, R.; Liu, Z.; Zhang, G.; Guo, N. Synergistic antimicrobial effects of nisin and p-Anisaldehyde on Staphylococcus aureus in pasteurized milk. LWT 2017, 84, 222–230. [Google Scholar] [CrossRef]
- Shin, J.; Na, K.; Shin, S.; Seo, S.-M.; Youn, H.J.; Park, I.-K.; Hyun, J. Biological activity of thyme white essential oil stabilized by cellulose nanocrystals. Biomolecules 2019, 9, 799. [Google Scholar] [CrossRef]
- Šegvić Klarić, M.; Kosalec, I.; Mastelić, J.; Piecková, E.; Pepeljnak, S. Antifungal activity of thyme (Thymus vulgaris L.) essential oil and thymol against moulds from damp dwellings. Lett. Appl. Microbiol. 2007, 44, 36–42. [Google Scholar] [CrossRef]
- Wahba, H.E.; Abd Rabbu, H.S.; Ibrahim, M.E. Evaluation of essential oil isolated from dry coriander seeds and recycling of the plant waste under different storage conditions. Bull. Natl. Res. Cent. 2020, 44, 192. [Google Scholar] [CrossRef]
- Senatore, F.; Oliviero, F.; Scandolera, E.; Taglialatela-Scafati, O.; Roscigno, G.; Zaccardelli, M.; De Falco, E. Chemical composition, antimicrobial and antioxidant activities of anethole-rich oil from leaves of selected varieties of fennel [Foeniculum vulgare Mill. ssp. vulgare var. azoricum (Mill.) Thell]. Fitoterapia 2013, 90, 214–219. [Google Scholar] [CrossRef] [PubMed]
- Bouyahya, A.; Mechchate, H.; Benali, T.; Ghchime, R.; Charfi, S.; Balahbib, A.; Burkov, P.; Shariati, M.A.; Lorenzo, J.M.; Omari, N.E. Health benefits and pharmacological properties of carvone. Biomolecules 2021, 11, 1803. [Google Scholar] [CrossRef] [PubMed]
- El-Zaeddi, H.; Martínez-Tomé, J.; Calín-Sánchez, Á.; Burló, F.; Carbonell-Barrachina, Á.A. Volatile composition of essential oils from different aromatic herbs grown in Mediterranean regions of Spain. Foods 2016, 5, 41. [Google Scholar] [CrossRef]
- Shahbazi, Y. Chemical composition and in vitro antibacterial activity of Mentha spicata essential oil against common food-borne pathogenic bacteria. J. Pathog. 2015, 2015, 916305. [Google Scholar] [CrossRef]
- Elmassry, M.M.; Kormod, L.; Labib, R.M.; Farag, M.A. Metabolome based volatiles mapping of roasted umbelliferous fruits aroma via HS-SPME GC/MS and peroxide levels analyses. J. Chromatogr. B 2018, 1099, 117–126. [Google Scholar] [CrossRef]
- Khrisanapant, P.; Kebede, B.; Leong, S.Y.; Oey, I. A comprehensive characterisation of volatile and fatty acid profiles of legume seeds. Foods 2019, 8, 651. [Google Scholar] [CrossRef] [PubMed]
- Zhou, Q.; Geng, F.; Deng, Q.; Huang, F.; Wang, J. Dynamic analysis of polar metabolites and volatile compounds in sesame seeds during roasting. Cereal Chem. 2019, 96, 358–369. [Google Scholar] [CrossRef]
- Boga, M.; Ozkan, E.E.; Ersoy, E.; Tuncay, E.; Canturk, Y.Y.; Cinar, E.; Kara, E.M.; Zengin, G. Identification and quantification of phenolic and volatile constituents in five different Anatolian Thyme species using LC–MS/MS and GC-MS, with biological activities. Food Biosci. 2021, 43, 101141. [Google Scholar] [CrossRef]
- Bernatoniene, J.; Kopustinskiene, D.M. The role of catechins in cellular responses to oxidative stress. Molecules 2018, 23, 965. [Google Scholar] [CrossRef]
- Gülçin, İ. Antioxidant activity of caffeic acid (3,4-dihydroxycinnamic acid). Toxicology 2006, 217, 213–220. [Google Scholar] [CrossRef] [PubMed]
- Xu, J.-G.; Hu, Q.-P.; Liu, Y. Antioxidant and DNA-protective activities of chlorogenic acid isomers. J. Agric. Food Chem. 2012, 60, 11625–11630. [Google Scholar] [CrossRef] [PubMed]
- Zduńska, K.; Dana, A.; Kolodziejczak, A.; Rotsztejn, H. Antioxidant properties of ferulic acid and its possible application. Skin Pharmacol. Physiol. 2018, 31, 332–336. [Google Scholar] [CrossRef]
- Enogieru, A.B.; Haylett, W.; Hiss, D.C.; Bardien, S.; Ekpo, O.E. Rutin as a potent antioxidant: Implications for neurodegenerative disorders. Oxid. Med. Cell. Longev. 2018, 2018, 6241017. [Google Scholar] [CrossRef]
- Zych, M.; Wojnar, W.; Borymski, S.; Szałabska, K.; Bramora, P.; Kaczmarczyk-Sedlak, I. Effect of rosmarinic acid and sinapic acid on oxidative stress parameters in the cardiac tissue and serum of type 2 diabetic female rats. Antioxidants 2019, 8, 579. [Google Scholar] [CrossRef]
- Sedeek, M.S.; Al-Mahallawi, A.M.; Hussien, R.A.A.; Ali, A.M.A.; Naguib, I.A.; Mansour, M.K. Hexosomal dispersion: A nano-based approach to boost the antifungal potential of Citrus essential oils against plant fungal pathogens. Molecules 2021, 26, 6284. [Google Scholar] [CrossRef]
- Wu, K.; Lin, Y.; Chai, X.; Duan, X.; Zhao, X.; Chun, C. Mechanisms of vapor-phase antibacterial action of essential oil from Cinnamomum camphora var. linaloofera Fujita against Escherichia coli. Food Sci. Nutr. 2019, 7, 2546–2555. [Google Scholar] [CrossRef] [PubMed]
- Kloucek, P.; Smid, J.; Frankova, A.; Kokoska, L.; Valterova, I.; Pavela, R. Fast screening method for assessment of antimicrobial activity of essential oils in vapor phase. Food Res. Int. 2012, 47, 161–165. [Google Scholar] [CrossRef]
- Chai, W.-M.; Liu, X.; Hu, Y.-H.; Feng, H.-L.; Jia, Y.-L.; Guo, Y.-J.; Zhou, H.-T.; Chen, Q.-X. Antityrosinase and antimicrobial activities of furfuryl alcohol, furfural and furoic acid. Int. J. Biol. Macromol. 2013, 57, 151–155. [Google Scholar] [CrossRef] [PubMed]
- Andrade, T.C.B.; LIMA, S.G.; Freitas, R.M.; Rocha, M.S.; Islam, T.; SILVA, T.G.; Militao, G.C.G. Isolation, characterization and evaluation of antimicrobial and cytotoxic activity of estragole, obtained from the essential oil of croton zehntneri (euphorbiaceae). An. Acad. Bras. Cienc. 2015, 87, 173–182. [Google Scholar] [CrossRef] [PubMed]
- Elsharawy, N.T. The Inhibition Effect of Thyme and Coriander Essential Oils on of Campylobacter Jejuni and Some of Their Virulence Genes on Chicken Burger and Chicken Shawerma Products. Glob. Adv. Res. J. Microbiol. 2018, 7, 104–112. [Google Scholar]
- El-Hawary, E.A.; Zayed, A.; Laub, A.; Modolo, L.V.; Wessjohann, L.; Farag, M.A. How does LC/MS compare to UV in coffee authentication and determination of antioxidant effects? Brazilian and Middle Eastern coffee as case studies. Antioxidants 2022, 11, 131. [Google Scholar] [CrossRef]
- Grzesik, M.; Naparło, K.; Bartosz, G.; Sadowska-Bartosz, I. Antioxidant properties of catechins: Comparison with other antioxidants. Food Chem. 2018, 241, 480–492. [Google Scholar] [CrossRef]
- Adomako-Bonsu, A.G.; Chan, S.L.F.; Pratten, M.; Fry, J.R. Antioxidant activity of rosmarinic acid and its principal metabolites in chemical and cellular systems: Importance of physico-chemical characteristics. Toxicol. Vitr. 2017, 40, 248–255. [Google Scholar] [CrossRef]
- Marimoutou, M.; Le Sage, F.; Smadja, J.; Lefebvre d’Hellencourt, C.; Gonthier, M.-P.; Silva, R.-D. Antioxidant polyphenol-rich extracts from the medicinal plants Antirhea borbonica, Doratoxylon apetalum and Gouania mauritiana protect 3T3-L1 preadipocytes against H2O2, TNFα and LPS inflammatory mediators by regulating the expression of superoxide dismut. J. Inflamm. 2015, 12, 10. [Google Scholar] [CrossRef]
- Li, N.; Jiang, L.; Liu, Y.; Zou, S.; Lu, M.; An, H. Metabolomics Combined with Transcriptomics Analysis Revealed the Amino Acids, Phenolic Acids, and Flavonol Derivatives Biosynthesis Network in Developing Rosa roxburghii Fruit. Foods 2022, 11, 1639. [Google Scholar] [CrossRef]
- Gentile, C.; Tesoriere, L.; Butera, D.; Fazzari, M.; Monastero, M.; Allegra, M.; Livrea, M.A. Antioxidant activity of Sicilian pistachio (Pistacia vera L. var. Bronte) nut extract and its bioactive components. J. Agric. Food Chem. 2007, 55, 643–648. [Google Scholar] [CrossRef] [PubMed]
- Aparadh, V.T.; Naik, V.V.; Karadge, B.A. Antioxidative properties (TPC, DPPH, FRAP, metal chelating ability, reducing power and TAC) within some Cleome species. Ann. Bot. 2012, 2, 49–56. [Google Scholar]
- Mulani, M.S.; Kamble, E.E.; Kumkar, S.N.; Tawre, M.S.; Pardesi, K.R. Emerging strategies to combat ESKAPE pathogens in the era of antimicrobial resistance: A review. Front. Microbiol. 2019, 10, 539. [Google Scholar] [CrossRef] [PubMed]
- Ibrahim, N.M.; Fahim, S.H.; Hassan, M.; Farag, A.E.; Georgey, H.H. Design and synthesis of ciprofloxacin-sulfonamide hybrids to manipulate ciprofloxacin pharmacological qualities: Potency and side effects. Eur. J. Med. Chem. 2022, 228, 114021. [Google Scholar] [CrossRef]
- Salem, M.A.; El-Shiekh, R.A.; Hashem, R.A.; Hassan, M. In vivo antibacterial activity of star anise (Illicium verum Hook.) Extract Using Murine MRSA skin infection model in relation to its metabolite profile. Infect. Drug Resist. 2021, 14, 33. [Google Scholar] [CrossRef]
- Farag, M.A.; Fathi, D.; Shamma, S.; Shawkat, M.S.A.; Shalabi, S.M.; El Seedi, H.R.; Afifi, S.M. Comparative metabolome classification of desert truffles Terfezia claveryi and Terfezia boudieri via its aroma and nutrients profile. LWT 2021, 142, 111046. [Google Scholar] [CrossRef]
- Farag, M.A.; Khattab, A.R.; Shamma, S.; Afifi, S.M. Profiling of primary metabolites and volatile determinants in mahlab cherry (Prunus mahaleb L.) seeds in the context of its different varieties and roasting as analyzed using chemometric tools. Foods 2021, 10, 728. [Google Scholar] [CrossRef]
- Farag, M.A.; Ramadan, N.S.; Shorbagi, M.; Farag, N.; Gad, H.A. Profiling of Primary Metabolites and Volatiles in Apricot (Prunus armeniaca L.) Seed Kernels and Fruits in the Context of Its Different Cultivars and Soil Type as Analyzed Using Chemometric Tools. Foods 2022, 11, 1339. [Google Scholar] [CrossRef]
- Bueno, J. Models of evaluation of antimicrobial activity of essential oils in vapour phase: A promising use in healthcare decontamination. Nat. Volatiles Essent. Oils 2015, 2, 16–29. [Google Scholar]
- Chen, Z.; Bertin, R.; Froldi, G. EC50 estimation of antioxidant activity in DPPH assay using several statistical programs. Food Chem. 2013, 138, 414–420. [Google Scholar] [CrossRef]
- Faso, B. DPPH Free Radical Scavenging Activity of Two Extracts from Agelanthus dodoneifolius (Loranthaceae) Leaves. Int. J. Toxicol. Pharmacol. Res. 2016, 8, 29–34. [Google Scholar]
- Preedy, V.R. Processing and Impact on Antioxidants in Beverages; Elsevier: Amsterdam, The Netherlands, 2014; ISBN 0124046959. [Google Scholar]
- Arnao, M.B.; Cano, A.; Acosta, M. The hydrophilic and lipophilic contribution to total antioxidant activity. Food Chem. 2001, 73, 239–244. [Google Scholar] [CrossRef]
- Schaich, K.M.; Tian, X.; Xie, J. Hurdles and pitfalls in measuring antioxidant efficacy: A critical evaluation of ABTS, DPPH, and ORAC assays. J. Funct. Foods 2015, 14, 111–125. [Google Scholar] [CrossRef]
- Liang, Z.; Cheng, L.; Zhong, G.-Y.; Liu, R.H. Antioxidant and antiproliferative activities of twenty-four Vitis vinifera grapes. PLoS ONE 2014, 9, e105146. [Google Scholar] [CrossRef] [PubMed]
- Shahidi, F. Handbook of Antioxidants for Food Preservation; Woodhead Publishing: Sawston, UK, 2015; ISBN 1782420975. [Google Scholar]
- Manivasagan, P.; Kim, S.K. Advances in Food and Nutrition Research; Elsevier: Amsterdam, The Netherlands, 2014. [Google Scholar]
- Benzie, I.F.F.; Strain, J.J. The ferric reducing ability of plasma (FRAP) as a measure of “antioxidant power”: The FRAP assay. Anal. Biochem. 1996, 239, 70–76. [Google Scholar] [CrossRef] [PubMed]
- Sudan, R.; Bhagat, M.; Gupta, S.; Singh, J.; Koul, A. Iron (FeII) Chelation, Ferric Reducing Antioxidant Power, and Immune Modulating Potential of Arisaema jacquemontii (Himalayan Cobra Lily). BioMed Res. Int. 2014, 2014, 179865. [Google Scholar] [CrossRef]
- Santos, J.S.; Brizola, V.R.A.; Granato, D. High-throughput assay comparison and standardization for metal chelating capacity screening: A proposal and application. Food Chem. 2017, 214, 515–522. [Google Scholar] [CrossRef]

| No. | RT (min) | Name | RI | EDT a | EDN b | SZT c | SZS d |
|---|---|---|---|---|---|---|---|
| 1 | 5.84 | 3-Hexen-1-ol | 807 | 0.01 ± 0.02 | 0.02 ± 0.01 | 0.02 ± 0.00 | 0.04 ± 0.01 |
| 2 | 8.01 | Linalool | 1083 | 0.32 ± 0.12 | 0.25 ± 0.12 | 0.17 ± 0.04 | 1.78 ± 0.32 |
| 3 | 8.78 | Borneol | 1162 | 0.00 ± 0.01 | 0.04 ± 0.02 | - | - |
| 4 | 8.96 | 4-Terpineol | 1170 | 0.73 ± 0.09 | 0.34 ± 0.08 | 0.17 ± 0.00 | 0.07 ± 0.01 |
| 5 | 9.03 | p-Cymene-8-ol | 1175 | 0.24 ± 0.05 | 0.24 ± 0.03 | 0.03 ± 0.01 | 0.07 ± 0.03 |
| Alcohols | Total | 1.30 | 0.89 | 0.40 | 1.97 | ||
| 6 | 4.17 | Hexanal | 734 | 0.04 ± 0.02 | 0.02 ± 0.01 | 0.01 ± 0.00 | 0.01 ± 0.00 |
| 7 | 6.70 | Benzaldehyde | 937 | 0.75 ± 0.04 | 1.43 ± 0.50 | 0.93 ± 0.03 | 0.49 ± 0.04 |
| 8 | 7.24 | n-Octanal | 984 | 0.42 ± 0.15 | 0.74 ± 0.16 | 1.98 ± 0.11 | 1.67 ± 0.29 |
| 9 | 8.09 | Nonanal | 1091 | 0.02 ± 0.00 | 0.05 ± 0.01 | - | 0.02 ± 0.00 |
| 10 | 9.59 | Cumin aldehyde | 1234 | 1.94 ± 0.36 | 1.04 ± 0.16 | 0.04 ± 0.03 | 0.54 ± 0.15 |
| 11 | 9.73 | p-Anisaldehyde | 1247 | 0.62 ± 0.15 | 0.23 ± 0.06 | 1.63 ± 0.11 | 7.51 ± 2.12 |
| Aldehydes | Total | 3.79 | 3.50 | 4.59 | 10.24 | ||
| 12 | 6.48 | Styrene | 853 | 0.18 ± 0.14 | 0.36 ± 0.11 | 0.20 ± 0.12 | 0.46 ± 0.10 |
| 13 | 7.27 | β-Cymene | 1003 | 0.02 ± 0.01 | 0.02 ± 0.02 | 0.05 ± 0.01 | 0.06 ± 0.03 |
| 14 | 7.99 | p-Dimethylstyrene | 1080 | 0.42 ± 0.16 | 0.22 ± 0.01 | 0.11 ± 0.00 | 0.22 ± 0.05 |
| 15 | 11.81 | α-Curcumene | 1461 | 0.85 ± 0.36 | 0.56 ± 0.10 | 0.20 ± 0.05 | 0.13 ± 0.04 |
| Aromatics | Total | 1.46 | 1.17 | 0.56 | 0.88 | ||
| 16 | 6.87 | n-Caproic acid | 955 | 0.72 ± 0.11 | 1.66 ± 0.09 | 0.43 ± 0.04 | 0.34 ± 0.03 |
| 17 | 8.74 | n-Caprylic acid | 1149 | 0.11 ± 0.04 | 0.21 ± 0.02 | 0.06 ± 0.01 | 0.04 ± 0.01 |
| Carboxylic acids | Total | 0.83 | 1.87 | 0.50 | 0.37 | ||
| 18 | 9.49 | Fenchyl acetate | 1226 | 0.02 ± 0.01 | 0.02 ± 0.01 | 0.02 ± 0.02 | 0.01 ± 0.00 |
| 19 | 10.60 | Terpinyl acetate | 1339 | 0.24 ± 0.08 | 1.96 ± 0.25 | 0.01 ± 0.01 | 0.13 ± 0.03 |
| 20 | 10.84 | Geranyl acetate | 1364 | 0.19 ± 0.07 | 1.09 ± 0.00 | 0.01 ± 0.01 | 0.11 ± 0.02 |
| 21 | 11.36 | Ethyl linoleate | 1453 | 0.32 ± 0.06 | 0.16 ± 0.03 | 0.11 ± 0.01 | 0.03 ± 0.01 |
| 22 | 11.79 | Methyl linolelaidate | 1459 | 0.20 ± 0.09 | 0.06 ± 0.09 | 0.06 ± 0.01 | 0.03 ± 0.00 |
| Esters | Total | 0.97 | 3.30 | 0.21 | 0.31 | ||
| 23 | 7.35 | Cineole | 1020 | 0.25 ± 0.09 | 0.60 ± 0.06 | 0.03 ± 0.02 | 0.21 ± 0.03 |
| 24 | 9.15 | Estragole | 1188 | 35.45 ± 1.17 c,d | 28.97 ± 4.26 c,d | 2.84 ± 0.97 a,b | 9.10 ± 2.45 a,b |
| 25 | 9.42 | O-Methylthymol | 1222 | 0.01 ± 0.00 | 0.51 ± 0.40 | - | - |
| 26 | 10.02 | Anethole | 1277 | 17.43 ± 1.99 | 7.51 ± 1.94 | 13.64 ± 0.10 | 25.40 ± 14.22 |
| Ethers | Total | 53.14 | 37.60 | 16.51 | 34.71 | ||
| 27 | 4.69 | Furfural | 777 | 0.01 ± 0.02 | 0.13 ± 0.10 | 0.54 ± 0.07 | 0.52 ± 0.03 |
| 28 | 6.71 | 5-Methyl-2-Furaldehyde | 942 | 1.62 ± 0.08 | 3.07 ± 0.42 | 1.67 ± 0.16 | 0.89 ± 0.04 |
| 29 | 7.64 | Furaneol | 1043 | 0.04 ± 0.01 | 0.07 ± 0.04 | 0.36 ± 0.08 | 0.12 ± 0.03 |
| 30 | 7.83 | 5-formylfurfural | 1065 | 0.37 ± 0.00 | 2.11 ± 1.13 | 0.12 ± 0.02 | 0.13 ± 0.03 |
| 31 | 9.38 | 5-Hydroxymethylfurfural | 1211 | 0.44 ± 0.18 | 4.59 ± 3.86 | 0.08 ± 0.04 | 0.12 ± 0.02 |
| Furans | Total | 2.48 | 9.96 | 2.76 | 1.78 | ||
| 32 | 8.00 | Fenchone | 1082 | 0.03 ± 0.02 | 0.01 ± 0.01 | 0.01 ± 0.00 | 0.17 ± 0.01 |
| 33 | 8.19 | Maltol | 1103 | 0.38 ± 0.06 | 0.83 ± 0.42 | 0.03 ± 0.01 | 0.20 ± 0.01 |
| 34 | 8.64 | Camphor | 1141 | 0.47 ± 0.00 | 1.24 ± 0.17 | 0.02 ± 0.00 | 0.26 ± 0.04 |
| 35 | 9.16 | Dihydrocarvone | 1197 | 0.62 ± 0.06 | 0.48 ± 0.16 | 0.03 ± 0.02 | 0.19 ± 0.08 |
| 36 | 9.63 | Carvone | 1237 | 12.09 ± 3.30 c,d | 14.83 ± 5.58 c,d | 1.06 ± 0.30 a,b,d | 4.77 ± 1.15 a,b,c |
| Ketones | Total | 13.58 | 17.38 | 1.16 | 5.58 | ||
| 37 | 6.52 | α-Thujene | 906 | 0.10 ± 0.00 | 0.43 ± 0.35 | 0.41 ± 0.37 | 0.99 ± 0.33 |
| 38 | 6.69 | Camphene | 925 | 0.04 ± 0.04 | 0.25 ± 0.35 | 0.07 ± 0.02 | 0.05 ± 0.04 |
| 39 | 6.93 | β-Myrcene | 961 | 6.95 ± 1.89 c,d | 7.62 ± 0.57 c,d | 19.49 ± 1.01 a,b | 16.15 ± 2.79 a,b |
| 40 | 7.23 | β-Pinene | 971 | 1.89 ± 0.47 | 2.08 ± 0.17 | 5.44 ± 0.27 | 4.54 ± 0.78 |
| 41 | 7.26 | α-Terpinene | 1002 | 0.21 ± 0.06 | 0.23 ± 0.02 | 0.60 ± 0.03 | 0.51 ± 0.08 |
| 42 | 7.31 | D-Limonene | 1016 | 6.44 ± 0.76 d | 6.06 ± 1.65 d | 5.55 ± 0.56 d | 9.06 ± 0.71 a,b,c |
| 43 | 7.35 | β-cis-Ocimene | 1027 | 0.18 ± 0.02 | 0.49 ± 0.00 | 0.04 ± 0.00 | 0.15 ± 0.02 |
| 44 | 7.45 | β-Ocimene | 1033 | 0.16 ± 0.04 | 0.37 ± 0.04 | 0.04 ± 0.00 | 0.17 ± 0.05 |
| 45 | 7.58 | γ-Terpinene | 1042 | 0.24 ± 0.11 | 0.27 ± 0.06 | 0.15 ± 0.02 | 0.06 ± 0.06 |
| 46 | 8.45 | Neo-allo-ocimene | 1117 | 0.03 ± 0.02 | 0.04 ± 0.02 | 0.01 ± 0.00 | 0.02 ± 0.00 |
| Monoterpene hydrocarbons | Total | 16.23 | 17.84 | 31.78 | 31.70 | ||
| 47 | 4.68 | 2-Methylpyrazine | 763 | 0.05 ± 0.08 | 0.09 ± 0.08 | 0.05 ± 0.03 | 0.03 ± 0.00 |
| 48 | 6.49 | 2,5-Dimethylpyrazine | 876 | 0.06 ± 0.02 | 0.48 ± 0.23 | 0.47 ± 0.18 | 0.71 ± 0.46 |
| 49 | 7.70 | α-Aminoxypropionic acid | 1056 | 0.04 ± 0.06 | 0.07 ± 0.08 | 0.08 ± 0.00 | 0.03 ± 0.03 |
| Nitrogen-containing compounds | Total | 0.16 | 0.64 | 0.60 | 0.77 | ||
| 50 | 7.82 | Linalool oxide | 1062 | 0.22 ± 0.01 | 1.26 ± 0.68 | 0.07 ± 0.01 | 0.10 ± 0.01 |
| Oxides | Total | 0.22 | 1.26 | 0.07 | 0.10 | ||
| 51 | 10.10 | Carvacrol | 1287 | 3.91 ± 1.18 c | 2.67 ± 0.53 c | 37.43 ± 4.33 a,b,d | 8.84 ± 1.76 c |
| Phenols | Total | 3.91 | 2.67 | 37.43 | 8.84 | ||
| 52 | 8.57 | Pyranone | 1133 | 0.02 ± 0.00 | 0.31 ± 0.25 | 0.01 ± 0.00 | 0.02 ± 0.01 |
| Pyrans | Total | 0.02 | 0.31 | 0.01 | 0.02 | ||
| 53 | 7.25 | Pyrrole-2-aldehyde | 991 | 0.61 ± 0.16 | 0.63 ± 0.30 | 2.94 ± 0.13 | 2.49 ± 0.44 |
| 54 | 8.24 | 2-Formyl-1-methylpyrrole | 1110 | 0.03 ± 0.02 | 0.18 ± 0.04 | 0.08 ± 0.01 | 0.10 ± 0.03 |
| Pyrroles | Total | 0.65 | 0.81 | 3.02 | 2.58 | ||
| 55 | 10.53 | δ-EIemene | 1332 | 0.03 ± 0.01 | 0.11 ± 0.02 | 0.02 ± 0.00 | 0.02 ± 0.00 |
| 56 | 10.98 | Bourbonene | 1383 | 0.13 ± 0.05 | 0.18 ± 0.03 | 0.02 ± 0.01 | 0.04 ± 0.00 |
| 57 | 11.33 | β-Caryophyllene | 1416 | 1.03 ± 0.21 | 0.49 ± 0.11 | 0.36 ± 0.03 | 0.11 ± 0.02 |
| 58 | 11.34 | Himachalene | 1443 | 0.06 ± 0.02 | 0.02 ± 0.01 | 0.02 ± 0.00 | - |
| Sesquiterpene hydrocarbons | Total | 1.25 | 0.80 | 0.42 | 0.17 | ||
| Compound | Rt (min) | EDT | EDN | SZT | SZS | ||||
|---|---|---|---|---|---|---|---|---|---|
| Mean | SD | Mean | SD | Mean | SD | Mean | SD | ||
| Gallic acid | 4.1 | 0.9 D | 0.00 | 2.0 C | 0.03 | 9.6 B | 0.03 | 21.3 A | 0.09 |
| Protocatechuic acid | 7 | 13.6 A | 0.22 | 5.2 B | 0.10 | 5.2 B | 0.00 | 2.8 C | 0.06 |
| p-Hydroxybenzoic acid | 10.3 | 11.3 A | 0.24 | ND | ND | 1.9 C | 0.04 | 5.6 B | 0.05 |
| (Epi)Catechin | 11.9 | 14.7 A | 0.16 | ND | ND | 14.8 A | 0.04 | 3.9 B | 0.53 |
| Chlorogenic acid | 12.8 | 2.37 B | 0.04 | ND | ND | 1.3 C | 0.00 | 2.5 A | 0.02 |
| Caffeic acid | 13.9 | 194.4 A | 0.19 | 31.0 D | 0.07 | 89.4 B | 0.28 | 63.6 C | 1.61 |
| Syringic acid | 14.9 | 23.1 A | 0.14 | 0.3 C | 0.00 | 1.5 B | 0.02 | 1.4 B | 0.09 |
| Vanillic acid | 16.7 | 2.8 B | 0.01 | 0.6 D | 0.02 | 3.9 A | 0.07 | 1.2 C | 0.05 |
| Ferulic acid | 21 | 325.8 A | 0.23 | 18.9 D | 0.07 | 91.3 B | 0.14 | 31.7 C | 0.26 |
| Sinapic acid | 21.8 | 28.8 A | 0.11 | 2.6 D | 0.05 | 5.4 B | 0.01 | 3.8 C | 0.11 |
| Rutin | 24.4 | 302.1 A | 0.89 | 12.5 D | 0.59 | 68.6 B | 0.43 | 29.0 C | 0.13 |
| p-Coumaric acid | 27.1 | 2.4 C | 0.06 | 4.1 B | 0.11 | 2.7 C | 0.09 | 10.5 A | 0.32 |
| Apigenin-7-O-glucoside | 28.8 | 7.8 | 0.29 | ND | ND | ND | ND | ND | ND |
| Rosmarinic acid | 30.2 | 338.3 A | 1.62 | 22.6 D | 0.38 | 149.6 B | 0.06 | 34.7 C | 0.33 |
| Daidzein | 34 | 26.8 A | 0.22 | 1.4 C | 0.11 | ND | ND | 5.1 B | 0.13 |
| Cinnamic acid | 35.6 | 11.0 A | 0.03 | 1.1 C | 0.02 | 1.3 B | 0.02 | 0.3 D | 0.03 |
| Quercetin | 36.4 | 3.9 C | 0.00 | 4.4 B | 0.04 | 5.6 A | 0.17 | 5.7 A | 0.13 |
| Genistin | 39 | 9.7 A | 0.04 | 3.2 C | 0.08 | 4.9 B | 0.01 | ND | ND |
| Kaempferol | 40.8 | 2.8 A | 0.07 | ND | ND | 1.1 B | 0.06 | 1.1 B | 0.00 |
| Vapor-Phase Minimum Inhibitory Concentration (VP-MIC) mg/mL | |||||||||
|---|---|---|---|---|---|---|---|---|---|
| Mix | Enterococcus faecalis ATCC19433 | Staphylococcus aureus Newman | MRSA USA300 | Klebsiella pneumoniae ATCC13883 | Acinetobacter baumannii AB5075 | Pseudomonas aeruginosa PAO1 | Enterobacter cloacae | Escherichia coli ATCC87 | Salmonella typhi ATCC 35664 |
| Th | * | 1.8 ± 1 | 2.4 ± 0 | 2 ± 0.7 | * | 1.2 ± 1 | 4.7 ± 0 | 2 ± 0.7 | 4.7 ± 0 |
| Su | * | 2.4 ± 0 | 2.4 ± 0 | 1.6 ± 0.7 | 4.7 ± 0 | 2.4 ± 2 | * | 3.1 ± 1.4 | 2 ± 0.7 |
| Cr | * | 1.2 ± 0 | 1.2 ± 0 | 1.2 ± 0 | 2.4 ± 2 | 1.2 ± 0 | 1.6 ± 0.7 | 2 ± 0.7 | 1 ± 0.3 |
| Cp | * | 3.5 ± 2 | * | 3.5 ± 2 | * | * | * | 4.7 ± 0 | 4.7 ± 0 |
| EDT | * | 2.4 ± 0 | 2.4 ± 0 | 2.4 ± 0 | 2.4 ± 0 | 2.4 ± 0 | 3.1 ± 1.4 | 4.7 ± 0 | 2.4 ± 0 |
| EDN | 3.1 ± 1.4 | 0.8 ± 0.3 | 0.8 ± 0.3 | 3.1 ± 1.4 | 2.4 ± 0 | 1.2 ± 0 | 2.0 ± 0.7 | 0.8 ± 0.3 | 0.8 ± 0.3 |
| SZT | * | 2.4 ± 0 | 2.4 ± 0 | 2.4 ± 0 | 2.4 ± 0 | 2.4 ± 0 | * | 2.4 ± 0 | 2.4 ± 0 |
| SZS | * | 4.7 ± 0 | 4.7 ± 0 | 4.7 ± 0 | 4.7 ± 0 | 4.7 ± 0 | * | 4.7 ± 0 | 4.7 ± 0 |
| Tested Mixtures | DPPH Assay | ABTS Assay | ORAC Assay | FRAP Assay | Ferrozine Iron Metal Chelation Assay |
|---|---|---|---|---|---|
| μM T eq/mg | μM T eq/mg | μM T eq/mg | μM T eq/mg | μM EDTA eq/mg | |
| EDT | 59.93 ± 1.99 | 225.32 ± 6.15 | 1577.86 ± 50.14 | 145.26 ± 4.32 | 51.69 ± 5.33 |
| EDN | 26.92 ± 0.75 | 125.15 ± 5.92 | 1303.68 ± 92.02 | 59.89 ± 2.33 | 22.26 ± 2.38 |
| SZS | 86.79 ± 1.38 | 263.52 ± 9.7 | 1138.11 ± 83.03 | 144.81 ± 7.95 | 19.30 ± 0.52 |
| SZT | 104.10 ± 1.68 | 337.26 ± 13.84 | 1479.09 ± 88.19 | 212.75 ± 12.85 | 18.08 ± 1.62 |
Publisher’s Note: MDPI stays neutral with regard to jurisdictional claims in published maps and institutional affiliations. |
© 2022 by the authors. Licensee MDPI, Basel, Switzerland. This article is an open access article distributed under the terms and conditions of the Creative Commons Attribution (CC BY) license (https://creativecommons.org/licenses/by/4.0/).
Share and Cite
Sedeek, M.S.; Afifi, S.M.; Mansour, M.K.; Hassan, M.; Mehaya, F.M.; Naguib, I.A.; Abourehab, M.A.S.; Farag, M.A. Unveiling Antimicrobial and Antioxidant Compositional Differences between Dukkah and Za’atar via SPME-GCMS and HPLC-DAD. Molecules 2022, 27, 6471. https://doi.org/10.3390/molecules27196471
Sedeek MS, Afifi SM, Mansour MK, Hassan M, Mehaya FM, Naguib IA, Abourehab MAS, Farag MA. Unveiling Antimicrobial and Antioxidant Compositional Differences between Dukkah and Za’atar via SPME-GCMS and HPLC-DAD. Molecules. 2022; 27(19):6471. https://doi.org/10.3390/molecules27196471
Chicago/Turabian StyleSedeek, Mohamed S., Sherif M. Afifi, Mai K. Mansour, Mariam Hassan, Fathy M. Mehaya, Ibrahim A. Naguib, Mohammed A.S. Abourehab, and Mohamed A. Farag. 2022. "Unveiling Antimicrobial and Antioxidant Compositional Differences between Dukkah and Za’atar via SPME-GCMS and HPLC-DAD" Molecules 27, no. 19: 6471. https://doi.org/10.3390/molecules27196471
APA StyleSedeek, M. S., Afifi, S. M., Mansour, M. K., Hassan, M., Mehaya, F. M., Naguib, I. A., Abourehab, M. A. S., & Farag, M. A. (2022). Unveiling Antimicrobial and Antioxidant Compositional Differences between Dukkah and Za’atar via SPME-GCMS and HPLC-DAD. Molecules, 27(19), 6471. https://doi.org/10.3390/molecules27196471

